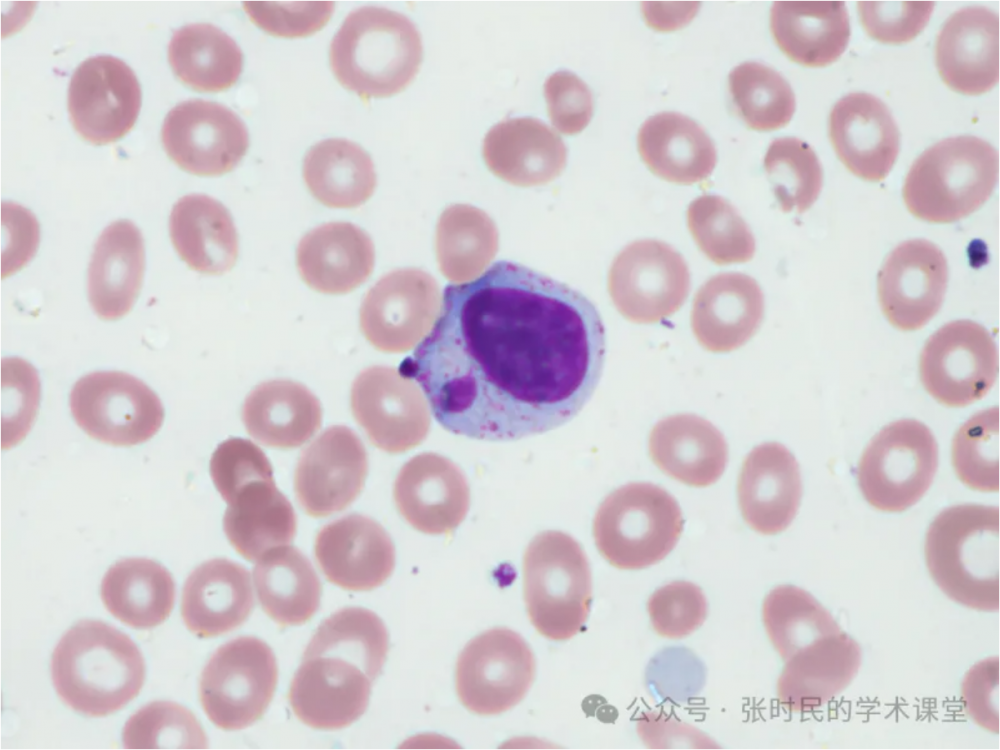
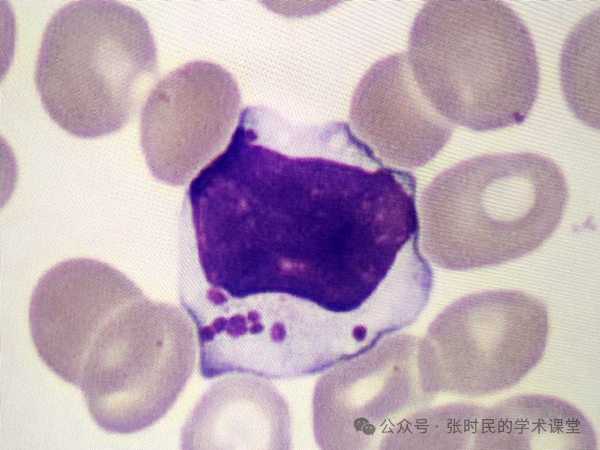

一个少有人关注的形态学发现
01形态学图像
淋巴细胞微核(Lymphocyte micronuleus),很少有人关注这个形态学发现,也找不到太多的图片资料。最近在工作中发现并拍照两幅典型的图片(图1-2),首先在此呈现给大家。在作者于2016年出版的《血象-外周血细胞图谱》中也包含有四幅淋巴细胞微核的图片
(图3-6)一并呈现给大家,但是并没有对其进行细致介绍。

图1 淋巴细胞微核

图2 淋巴细胞微核
图3 淋巴细胞微核(圆形,胞浆内可见明紫红色颗粒)

图4 淋巴细胞微核(这个微核圆形,胞浆可见紫红色颗粒,偏大,但小于主核的1/3)

图5 淋巴细胞微核(胞浆中可见少许紫红色颗粒)

图6 淋巴细胞微核(这个微核呈椭圆形)
在我国《临床检验基础》教材第五版中将这形态称为卫星核淋巴细胞(satellite nucleus),并配合图片(图7)

通过网络搜索关键词(Lymphocyte micronuleus)可以找到一些图片(图8-13),但检索卫星核淋巴细胞(satellite nucleus),则找不到典型的外周血中的此类细胞,看来国外普遍认同微核的概念。

图8 两个淋巴细胞,其中一个是分裂核淋巴细胞,都含有微核(可能不是外周血涂片标本)

图9 外周血片中的淋巴细胞微核

图10 外周血中的淋巴细胞微核

图11 外周血中的椭圆形微核

图12 某标本中分裂的淋巴细胞及多个微核

图13 电子显微镜下的分裂核淋巴细胞及微核(箭头)
02形成原理
微核(micronucleus)也叫卫星核,国内教科书将其称为卫星核淋巴细胞。
是真核类生物细胞中的一种异常结构;
是染色体畸变间期细胞中的一种表现形式;
在淋巴细胞中发现就叫淋巴细胞微核,在其他细胞中也有发现。
图14示意了淋巴细胞微核的形成过程,在细胞有丝分裂间期,微核呈圆形或椭圆形,游离于主核之外,大小应在主核1/3以下。微核的折光率及细胞化学反应性质和主核一样,也具合成DNA的能力。一般认为微核是由有丝分裂后期丧失着丝粒的染色体断片而产生的。

图14 淋巴细胞微核的形成示意图
在我国《临床检验基础》本科教科书上是这样描述的:因染色体损伤,丧失着丝点的染色单体或其片段在有丝分裂末期,未进入子代谢细胞遗传物质体内而形成。
在国外资料中还有如图15这样的形态和描述:
英文原文:(a–f) Micronuclei and nuclear buds in human lymphocytes. (a) A binucleated cell with a micronucleus (on the right) and two nuclear buds (on the left) indicated by an arrow; the lower nuclear bud is surrounded by a vacuole. (b–d) BN cells with nuclear buds. Trinucleated cells with one small nucleus that resembles a micronucleus but has a diameter greater than one-third the large diameter of the two main nuclei. Reprinted from Fenech et al. [29] with permission of Elsevier.
译文:图15(a–f)为人类淋巴细胞中的微核和核芽。图15(a) 一个双核细胞,带有微核(右侧)和两个核芽(左侧),如箭头所示;下核芽被液泡包围。图15(b–d)具有核芽的BN细胞。三核细胞,有一个小核,类似于微核,但直径大于两个主要核大直径的三分之一。

图15 来自国外的文献插图
(注释:这里面提到一个名词“核芽”,作者理解为尚未完全脱离主细胞核的,尚有丝状连接的微核结构,如图14的b、c、d)
03参考范围和临床意义
01>>国内教科书尚无参考范围,经过网络检索,认为正常人这种含微核的淋巴细胞应<6/1000,特指1000个淋巴细胞中所含淋巴细胞微核的数量,而不是所有白细胞中所含淋巴细胞微核的数量。因此从事这项检验是比较耗费时间与功夫的。现在已经有了图像法血细胞形态分析设备,如果能启用自动扫描,通过AI识别,人工复检鉴定,或许可以提高识别效率。
02>>出现这种淋巴细胞微核现象往往是各种理化因子,如辐射、放射及化学药剂对分裂的细胞作用而产生的现象。一般认为正常人血液中的微核细胞在千分之六以下,如果太高可能与放射损伤有关,所以针对从事放射性工作的人或受到放射性辐射的人,需要定期观察血涂片中这类淋巴细胞微核的比例。
03>>《临床检验基础》第五版中写道的临床意义:常见于接受较大剂量的电离辐射、核辐射之后,或其他理化因素、抗癌药物等早的细胞损伤。常作为致畸、致突变的客观指标之一。
04>>《临床检验基础》第三版教科书上还写道:放射损伤后淋巴细胞形态变化,淋巴细胞是白细胞中对电离辐射最敏感的细胞。人体遭受小剂量电离辐射之后,虽未出现明显临床症状,但血液中淋巴细胞数量却已显著减低。若经过较大剂量照射后,淋巴细胞迅速减低,剂量越大,减低的越严重以致衰竭。与此同时受到损伤的淋巴细胞还会出现形态学改变,如核固缩、核破碎、双核的淋巴细胞及含有卫星核的淋巴细胞。后者是指细胞质中主核旁出现小核,也称微核,是射线损伤后较为特殊的所见。
03
小 结
曾有人提问,淋巴细胞微核与大颗粒淋巴细胞如何鉴别?
作者理解为
大颗粒淋巴细胞是指含有明显紫红色颗粒的正常淋巴细胞,而不是核。颗粒更细小,而且数量较多,不规则散布在细胞浆内,见图16-18。
而淋巴细胞微核多数只有一个核,较大,但小于主核的1/3,圆形或椭圆形(如上面的例图),因此不要将大颗粒淋巴细胞与微核混淆。

图16 大颗粒淋巴细胞
图17 大颗粒淋巴细胞

图18 大颗粒淋巴细胞
淋巴细胞微核是一种独特的现象,纵观文献和教科书,都指向放射损伤或者放射病,也包括放射治疗的病人。
因此在观看血片时,如果见到这种含淋巴细胞微核的细胞,可以了解一下病人临床治疗情况。
据了解在某些职业病体检中,针对从事放射性工作的人员,有淋巴细胞微核率这项检验项目,在一般医院常规检验中不开展这个项目。
内容来源 | 张时民的学术课堂
图片来源 | veer、ibaotu
排版 | znm
审校 | 金宝

